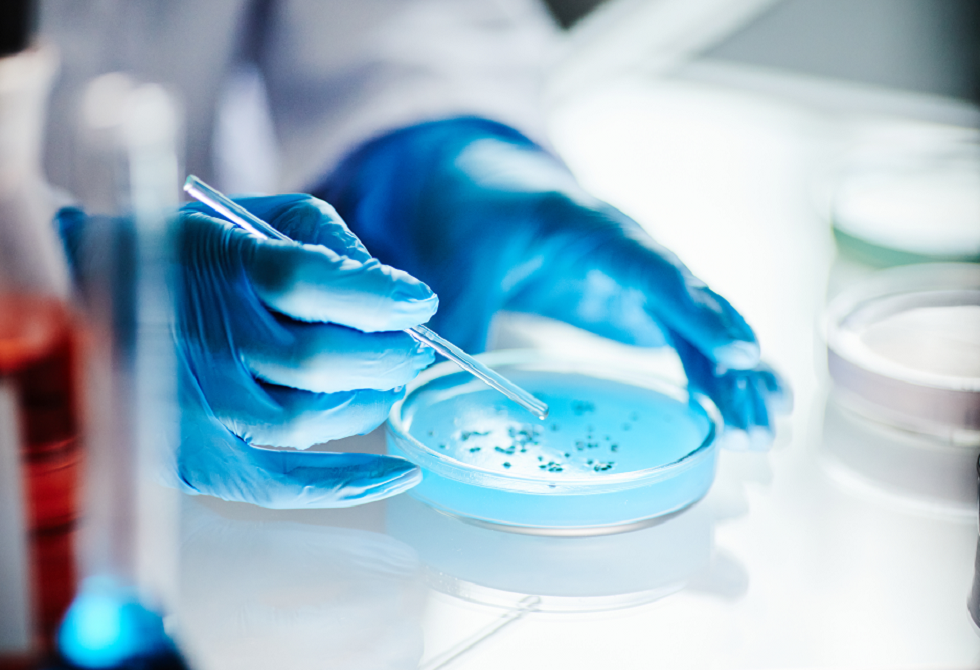

عادات تدمر لك جهاز اللاب توب
مع أن لقب أكثر الأجهزة الإلكترونية إساءة للاستخدام يعود بوضوح للهواتف الذكية، فالحواسيب المحمولة تأتي في مرتبة ثانية قريبة.
حيث من المعتاد أن يقوم المستخدمون بالإضرار بهذه الأجهزة الإلكترونية وإهمالها بشدة.
ومع أن الحواسيب المحمولة تصمد لسنوات عديدة من الاستخدام عادة، يعرف الجميع أن تجربة استخدامها تتراجع بسرعة مع الوقت.
وبالإضافة لكون العتاد أقدم عادة ما يكون جزء كبير من المشكلة هو إساءة الاستخدام.
-استخدام الحاسوب على أسطح غير ملساء
-ترك الغبار وسواه يتراكم بين المفاتيح
-تفريغ البطارية بشكل متكرر
-التعامل بإهمال مع المنافذ